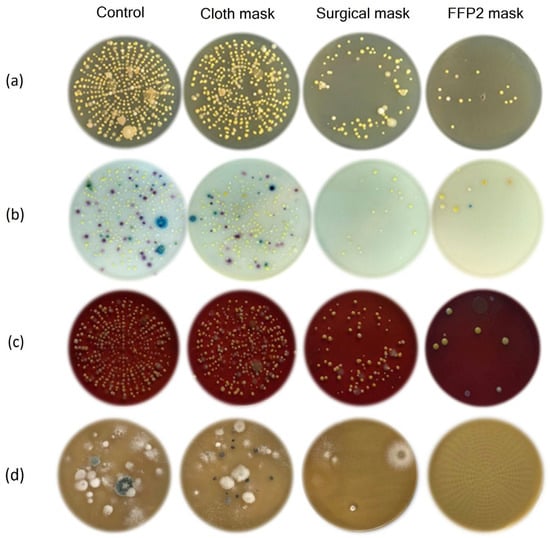

Abstract
Emerging infectious diseases that we are witnessing in the modern age are among the leading public health concerns. They most often occur in the form of epidemics or pandemics, and they have not been sufficiently researched. Owing to the current coronavirus disease 2019 (COVID-19) pandemic, the World Health Organization has published various recommendations to prevent the spread of this communicable disease, including a recommendation to wear protective facial masks. Therefore, this study aimed to determine the filtration effectiveness of bacteria, yeasts, and molds on three different commonly and commercially available masks used in children’s educational institutions. In addition, the bacterial content of indoor air bioaerosols was identified. The genera Staphylococcus and Micrococcus were dominant in all samples, whereas bacteria of the genera Bacillus, Acinetobacter, and Corynebacterium were identified at a significantly smaller number. Bacterial, yeast, and mold filtering effectiveness increased from the single-layer cloth mask, which proved to be the least effective, to the surgical mask, to the filtering facepiece type 2 (FFP2) mask. Furthermore, surveys are needed to study the effectiveness of protective measures.
1. Introduction
The world is currently witnessing an emerging infectious disease called coronavirus disease 2019 (COVID-19), which appeared in the form of a pandemic. It is caused by severe acute respiratory syndrome coronavirus-2 (SARS-CoV-2), and the main transmission routes of this virus are aerosols and droplets [1]. Due to its sudden appearance, high rate of spread, and difficulties in control, it poses significant challenges both in health and other aspects. The World Health Organization (WHO) has published various recommendations and measures to prevent this spread, including the recommendation to wear protective facial masks [2]. Most outbreaks involving three or more people have been linked to time spent indoors. To reduce indoor airborne transmission, it is necessary to perform control measures through source (masking and physical distancing) and engineering controls (ventilation and filtration) [3]. Following the basic ventilation standards for indoor spaces such as schools and kindergartens, we noticed that they are designed to dilute bio-effluents and achieve basic levels of acceptable indoor air quality rather than to control infection [4].
The main use of masks has been shown to help reduce the spread of contaminated droplets, which can cause various diseases. The prevention benefit of masking is derived from a combination of source control and wearer protection [5]. Bacterial filtration efficiency (BFE) is a parameter that classifies medical masks into two types: type I with a BFE ≥ 95% and type II masks with a BFE ≥ 98%, which conforms to the standard EN 14683:2019 [6]. Particle filtration efficiency (PFE), breathability and leakage, and carbon dioxide (CO2) content of inhaled air are some of the performance criteria of the EN149 standard under which filtering face piece (FFP) masks are regulated [7]. According to the PFE, FFPs can be classified into three types: FFP1, which has a PFE ≥ 80%; FFP2, which has a PFE ≥ 94%; and FFP3, which has a PFE ≥ 99%. Nevertheless, we often see surgical and simple man-made cloth masks in everyday use that do not meet this standard. Therefore, the filtering ability of masks depends on their specifications and external factors [8]. The main goal of studies conducted in this field is to determine mask filtration efficiency in eliminating bacterial or yeast and mold contamination of indoor air [9,10]. Many studies have reported the use of cloth, surgical, and FFP2 masks during the influenza pandemic [11,12] or the SARS-CoV-2 pandemic [13,14].
However, all available data have different methodologies and, consequently, result in different filtering mechanisms [15,16,17]. Despite its significant limitations, bioaerosol monitoring may be a useful tool for studying occupational exposure and the transmission of infectious diseases [18]. Therefore, this study aimed to evaluate bacterial, yeast, and mold filtration efficiency using three different types of masks commonly used in the public (single-layer fabric [cotton], classic surgical, and FFP2 nonreusable [NR] masks). To collect sufficiently contaminated indoor air from schools, kindergarten facilities were selected. In addition, this study aimed to estimate the internal air quality, microbiological exposure to bioaerosols in educational facilities, and the effectiveness of preventive measures.
2. Materials and Methods
2.1. Air Sampling Locations
Air samples were collected from four different groups of children: kindergarten (two groups: locations A and B) and primary schools (two groups: locations C and D). Air samples were collected during the children’s stay in kindergarten and during school classes to gain insight into the effectiveness of filtering masks for bacteria, yeasts, and molds present in the examined groups of these institutions. In the kindergarten groups, measurements were performed on the same day during daycare, while in the school, sampling was performed during live morning classes and the next day. In each group, a control measurement was performed, and it did not involve any type of mask and represented filtering without any protection. The experiments were conducted at the aforementioned locations in children groups, and the detailed information on the humidity, temperature, number of persons, and room size during the sampling procedure is presented in Table 1.

Table 1.
Sampling locations with exact values of humidity/%, temperature/°C, number of persons in the room, and room size.
2.2. Air Sampling Procedure
For air sampling, a MAS-100 NT® sampler (Merck, Darmstadt, Germany) was used. To obtain the highest quality in microbial air monitoring and collection efficiency, this system features a 300-hole perforated lid with standard 90–100 mm agar plates. The total sampling volume was adjusted to 250 L of air at an airflow velocity of 0.45 m/s with no turbulence in a laminar flow environment. The experimental setup is presented in the scheme in Figure 1a,b.

Figure 1.
Scheme of the experimental setup with sampling locations at (a) locations A and B, kindergarten rooms; and (b) locations C and D, primary school classrooms.
Because of the number of microorganisms, particles hitting the plate increase the probability that two particles pass through the same hole and only one colony is formed [19]. According to Feller, the table of statistical corrections is used to determine the number of microorganisms. Specifically, a correction was performed according to the following equation:
where Pr denotes the probable (statistical) total number of colonies, r is the number of colonies counted, and N is the number of holes on the device head (300).
2.3. Face Masks
Three types of face masks commonly and commercially available to purchase were used for this study: (a) single-layer fabric (cotton) (RT2 Ltd., Rijeka, Croatia), (b) classic surgical (Delt paper Ltd., Zagreb, Croatia), and (c) FFP2 NR masks (DM9501, LOT:603744, Filtering face piece No2, Innovative Material and Devices Inc., Shanghai, China). All the masks were purchased from stores for public use. The single-layer fabric mask is made of cotton, designed to be worn over the mouth and nose, and made with no standards or regulations. The classic surgical mask is made of a nonwoven fabric, usually polypropylene, with low breathing resistance. The FFP2 NR mask is made of two layers of high-quality melt-blown filter fiber and designed to fit closely to the face to achieve high filter performance.
2.4. Agar Plate Preparation and Bacterial Determination
Bacterial colony forming unit determination was based on the count of the collected microorganisms on tryptic soy agar (TSA) (Biolife, Monza, Italy) (total count), blood agar (Biolife, Italy) (specifically for Streptococcus species), and chromogenic BrillianceTM UTI agar (Oxoid, Basingstoke, UK) (bacterial differentiation), whereas colonies of yeasts and molds were counted on Sabouraud dextrose agar (Biolife, Italy). Nutrient medium was prepared according to the manufacturer’s instructions. TSA, chromogenic agar, and Sabouraud agar were suspended in cold distilled water, and the obtained suspensions were sterilized in an autoclave at 121 °C for 15 min. After cooling to 50 °C, the suspensions were poured into Petri dishes and left at room temperature (25 ± 1 °C). Blood agar was prepared in the same way, but after cooling to 50 °C, the suspension was enriched with 5% defibrillated sheep’s blood, mixed well, poured into Petri dishes, and left at room temperature (25 ± 1 °C). Upon the completion of air sampling, TSA and BrillianceTM UTI agar plates were incubated at a mean temperature of 36 ± 1 °C for 48 h. To detect yeasts and molds, Sabouraud dextrose agar plates were incubated at 30 °C for 10 days. After incubation, the total number of bacteria on TSA agar and yeasts and molds on the Sabouraud dextrose agar was determined. Presumptive bacterial identification of the bacterial colonies was performed on BrillianceTM UTI agar according to colony morphology and color, as instructed by the manufacturer. The grown colonies were pricked to obtain pure bacterial cultures, which were then identified based on a characteristic increase in blood, color changes on chromogenic urine agar, microscopic appearance, confirmatory standardized tests (catalase, coagulase, and oxidase test), and an identification system for staphylococcal isolates (API 20STAPH System, BioMerieux, Inc., Marcy-l’Étoile, France).
2.5. Data Analysis
The experimental data are presented as the mean values of three measurements, with the corresponding standard deviation. All statistical analyses were performed using Statistica® v. 14.0 software; (StatSoft Inc., Tulsa, OK, USA) at a significance level of p < 0.01. Differences between the control and experimental groups of bacteria and yeast were tested using the nonparametric Kruskal–Wallis (multiple comparisons) test. To analyze bacterial and yeast filtration efficiency using single-layer cloth, surgical, and FFP2 masks, all experimental groups were normalized to the control group, and differences were analyzed using the nonparametric Kruskal–Wallis (multiple comparisons) test and principal component analysis (PCA).
3. Results and Discussion
The data acquired from the investigation could determine which mask has the higher capacity or better efficiency in eliminating bioaerosols and optimal filtration of airborne particles. It seems that particle size distribution is an important factor influencing filtration efficiency determination, and it is necessary to determine the bacterial content of indoor air at educational facilities. To monitor the bioaerosol content of indoor air, as well as the bacterial and yeast filtration efficiency of the three different types of masks, air sampling at educational facilities was performed. A representative amount of air (250 L) was used to obtain a sufficient number of colonies for later identification. The number of total aerobic mesophilic bacterial colonies grown on TSA and chromogenic agar from analyzed locations A, B, C, and D after air filtration with the single-layer cloth, surgical, and FFP2 masks is presented in Figure 2a,b.

Figure 2.
Number of grown colonies of (a) aerobic mesophilic bacteria on tryptic soy agar (TSA) and (b) yeasts and molds on Sabouraud agar (SA) from four locations (A, B, C, D) in the control group after air filtration with cloth, surgical, and filtering facepiece type 2 (FFP2) masks expressed as colony forming unit (CFU)/250 L of air. The data are presented as mean values of three determinations with standard deviations. Mean values marked with capital letter A represent significant differences between the control group and each treatment with cloth, surgical, and FFP2 masks, while lowercase letters a and b represent significant differences within treatments (p < 0.01; nonparametric Kruskal–Wallis [multiple comparisons] test).
As shown in Figure 2a, the largest number of mesophilic bacterial colonies was recorded in the control samples of each experimental group, which is in the air samples where the efficiency of mask filtration was not tested. Filtration efficiency was defined as the ability of the masks to retain bacteria, yeast, and mold and is expressed as a percentage compared with that of the control group. Analysis of the differences in colony number between the control and treatment using the different masks showed a statistically significant efficiency of bacterial filtration for all treatments (p < 0.01). Among the masks tested, the single-layer cloth mask proved to be the least effective, retaining 28–78% of the mesophilic bacteria with the highest efficiency at location B (78%). On the other hand, the surgical and FFP2 masks showed a higher degree of filtration efficiency of the total aerobic mesophilic bacteria, from 93 to 98% and from 98 to 100%, respectively. The filtration efficiency of masks was also studied. Statistically significant filtering efficiency (p < 0.01) was observed at all locations between the single-layer cloth mask and the surgical and FFP2 masks, as well as between the surgical and FFP2 masks. It is difficult to find many published investigations regarding testing mask filtration efficiency in comparison with available data regarding clinical trials and public health investigations. It has been reported that the use of single-layer cloth masks can result in significantly higher rates of infection than can the use of surgical masks, with this information being obtained from a randomized trial in healthcare workers [20,21].
There are available data on fungi isolated from indoor environments [22], but information about yeasts and molds and their content in indoor air filtered through masks is insufficient.
The filtration efficiency for yeasts and molds of protective mask was also investigated, and the results are shown in Figure 2b. As with the group of filtered mesophilic bacteria, all masks proved effective in retaining yeasts and molds. The highest filtration efficiency was achieved with the use of the FFP2 mask (94–100%) and the lowest with the single-layer cloth mask (13–79%). All mask application treatments at all locations showed statistically significant filtration efficiency compared with that of the control group (p < 0.01). At location A, there was no statistical difference in filtration efficiency between the surgical and FFP2 masks (100% at both locations) or at location B between the single-layer cloth and surgical masks (79%). Further identification of yeast and mold species was not performed.
Since the normal human flora consists various of Gram-positive and negative bacterial strains, it is not expected that there would be predominantly bacteria present in the air, especially indoors and during the summer season, when human skin is more exposed. It was assumed that the bacterial species of Micrococcus spp., Staphylococcus spp., and Bacillus spp. prevailed indoors. For this reason, detailed identification of bacterial species present at each location was made after air filtration with masks. M. luteus was the most prevalent bacteria at all examined locations, followed by Acinetobacter lwoffi and S. haemolyticus (Table 2 and Table 3).

Table 2.
Number of grown colonies of different bacterial species on tryptic soy agar (TSA) from locations A and B in the control group after air filtration with cloth, surgical, and filtering facepiece type 2 (FFP2) masks expressed as colony forming unit (CFU)/250 L of air. The data are presented as mean values of three determinations with standard deviations. Mean values marked with capital letter A represent significant differences between the control group and each treatment with cloth, surgical, and FFP2 masks, while lowercase letters a and b represent significant differences within treatments (p < 0.01; nonparametric Kruskal–Wallis [multiple comparisons] test).

Table 3.
Number of grown colonies of different bacterial species on tryptic soy agar (TSA) from locations C and D in the control group after air filtration with cloth, surgical, and filtering facepiece type 2 (FFP2) masks expressed as colony forming unit (CFU)/250 L of air. Mean values marked with capital letter A represent significant differences between the control group and each treatment with cloth, surgical, and FFP2 masks, while lowercase letters a and b represent significant differences within treatments (p < 0.01; nonparametric Kruskal–Wallis [multiple comparisons] test).
Interestingly, the presence of M. luteus varied depending on the location, accounting for 40% of the total grown colony of all identified bacteria at locations A and C, while at locations B and D, this percentage was significantly higher at an average of 88%. M. luteus are Gram-positive cocci usually found in soil and water resources and other natural environments. In addition, the species is also considered to be a normal inhabitant of human skin and oropharynx mucosa [23]. This might be the reason for its greater prevalence at both school facilities, but this may also be the result of the filtration efficiency of the particular mask used for sampling. A slightly different situation was achieved with A. lwoffi and S. haemolyticus, which were found at higher amounts at locations A and C (19% and 20% on average for each bacteria) compared with that of locations B and D (6% and 3%). Furthermore, Bacillus spp., Micrococcus spp., and S. aureus were isolated at each location but at a smaller number of colonies (less than 10% of the total number of identified bacterial colonies). Among isolated bacteria, S. lentus was found only at two examined locations A and C, while Corynebacterium spp. and S. epidermidis were isolated at locations C and D. Although it seems that the location could be the reason for the presence or absence of some bacterial species, we believe that probably the lack of using preventive measures for improving the air quality was the main reason for the variable occurrence of different bacterial strains. S. chromogenes was not isolated only at location C. From the data shown in Table 2 and Table 3, it can be seen that the single-layer cloth mask showed a very poor filtering efficiency of M. luteus especially at locations A (6%) and D (20%) as compared to the control group, while significantly higher efficiency (p < 0.01) was observed at locations B (70%) and C (50%). A. lwoffi was retained in the single-layer cloth mask by 46% on average, Bacillus spp. by 44%, and S. haemolyticus by 30%. Interestingly, the single-layer cloth mask was effective in filtering Micrococcus spp. at locations A and B (100%), while at locations C and D, the efficiency was poor at only 21%. A similar situation was observed for S. aureus at location B with 100% filtering efficiency, while at the other locations, the efficiency was 52%. In general, the surgical masks were found to be effective in retaining most bacteria (over 90%) except for S. chromogenes and S. haemolyticus at location B, for which the efficacy was only 50 and 78%, respectively. Furthermore, at location D, the filtration efficiency of the surgical mask was lower and ranged from 60 to 67% for Corynebacterium spp., Bacillus spp., and S. haemolyticus. FPP2 masks showed a significant filtration efficiency, >96%, of all analyzed bacteria. However, they were somewhat ineffective in filtering Micrococcus spp. and S. chromogenes but only at location D, where an efficiency of 68% was found.
Furthermore, the filtering efficiency of the masks used was also analyzed depending on the location (A, B, C and D), and the results are shown in Figure 3a–c. From Figure 3, it can be seen that the highest oscillations in the filtration efficiency for bacteria depending on the location were exhibited by the single-layer cloth mask (Figure 3a). Slightly lower differences in air filtration by the single-layer cloth mask were achieved for bacterium A. lwoffi, while the worst efficiency was achieved at location A (31%, and the highest at location B (60%). Meanwhile, the single-layer cloth mask filtering efficiency was very similar at locations B and C (60 and 57%) and locations A and D (31 and 37%), where the mentioned locations did not show statistically significant differences. A similar situation was found in the filtration of Bacillus spp. and M. luteus bacteria, for which the lowest filtration efficiency was found at location A (28 and 6%) and the highest at location D (70% for both bacteria). The filtration efficiency of M. luteus and Bacillus spp, was significantly different between all locations except between locations A and C. S. haemolyticus was filtered with a single-layer cloth mask at an efficiency of 7 (location A) to 58% (location C), representing significant differences between locations. A very similar filtering efficiency was observed for Corynebacterium spp., ranging from 8 (location D) to 52% (location C), but it should be noted that this bacterium was not isolated at locations A and B. S. chromogenes was filtered most efficiently at location A (79%) and least efficiently at location B (29%), with the only evident difference being observed between locations A and B (p < 0.01).


Figure 3.
Differences in bacterial filtration efficiency between locations: kindergarten group A (location A), kindergarten group B (location B), primary school group A (location C), and primary school group B (location D) with the applied (a) cloth, (b) surgical, and (c) filtering facepiece type 2 (FFP2) masks expressed in percentage (%) as compared to the control group. The data are presented as mean values of three determinations with standard deviations. Mean values marked with lowercase letter a represent significant differences between location A and the other locations (locations B, C, and D), lowercase letter b represents significant differences between location B and locations C and D, while lowercase letter c represents significant differences between location C and location D (p < 0.01; nonparametric Kruskal–Wallis [multiple comparisons] test).
Higher bacterial filtration oscillations were observed in the remaining analyzed bacteria. Thus, Micrococcus spp. was filtered with an efficiency of 16 (location D) to 100% (locations A and B), S. aureus from 47 (location C) to 100% (location B), S. lentus from 15 (location A) to 100% (B), and S. epidermidis from 50 (location C) to 100% (location D). The results of bacterial filtration efficiency of the surgical mask are shown in Figure 3b. Much lower oscillations in filtration efficiency were observed with the surgical mask than with the single-layer cloth mask. The highest range in filtration efficiency was observed for S. haemolyticus from 65 (location C) to 90% (location A) with statistically significant differences between the different locations (p < 0.01). A similar situation was observed with M. Luteus (77% at location D and 98% at location C) and A. lwoffii (75% at location D and 97% at location A). The following are the bacteria for which the surgical mask achieved a filtration efficiency of 100% for at least one of the locations: Bacillus spp. from 67 (location D) to 100% (locations B and C), Corynebacterium spp. from 60 (location D) to 100% (location C), Micrococcus spp. from 68 (location D) to 100% (locations A and B), and S. chromogenes from 50 (location B) to 100% (locations A and D), with significantly different filtration efficiencies between individual locations (p < 0.01). The filtration efficiency for S. aureus, S. lentus, and S. epidermidis was 100% at all analyzed locations. FFP2 masks proved to be the most effective masks in filtering air, and the smallest differences in filtration efficiency were observed between the analyzed locations for individual bacteria. Thus, the bacteria Corynebacterium spp., S. aureus, S. lentus, and S. epidermidis were completely filtered at all analyzed locations (100%). Smaller oscillations in bacterial filtration efficiency were observed for S. haemolyticus at 80 (location D) to 100% (locations B and C), Bacillus spp. at 83 (location A) to 100% (locations B, C and D), A. lwoffii at 94 (location D) to 100% (locations A, B and C), and M. luteus at 96 (location A) to 100% (location B). The lowest efficiency of bacterial filtration with the FPP2 mask was achieved for Micrococcus spp. at 68 (location D) to 100% (locations A, B and C) and S. chromogenes at 67 (location D) to 100% (location B).
The abovementioned results collectively show that there are slight differences in the efficiency of the single-layer cloth mask filtration and it probably oscillates depending on the children’s age between the groups and the health condition of the individuals present at each location spatially. Moreover, previous air ventilation of the indoor area and children’s activity prior to the measurement might be important cause of some filtration differences measured within the bacterial strains. However, it is undoubtedly clear that this analysis has obtained results that confirm the efficiency of bacteria filtration increases from the single-layer cloth mask, which proved to be the least effective, to the surgical mask, to the FFP2 mask.
In their investigation, Whyte et al. [24] also concluded that the filtration efficiency is different for various sizes of aerosols. This study showed that the single-layer cloth masks currently available for purchase had a minimum filtration efficiency of 50%. Our findings also support the recommendations from the WHO on the use of fabric masks [2]. Information on the bacterial growth of the collected microorganisms on tryptic soy agar (TSA), chromogenic BrillianceTM UTI agar, and blood agar is presented in Figure 4a–c. Meanwhile, the information for yeast and mold growth on the Sabouraud agar on a control air sample and samples filtered with single-layer cloth, surgical, and FFP2 masks is shown in Figure 4d. The first medium showed the growth of yeasts and molds on the control medium, as well as the growth under filtration with single-layer cloth, surgical, and FFP2 masks. In all tested locations and treatments, the highest colony growth was recorded in the control medium. Similar to what occurred with the chromogenic agar and TSA, a single-layer cloth mask proved to be the least effective in filtering yeasts and molds, while the surgical mask proved to be the second least effective. No yeast or mold colonies were recorded after the air was filtered with the FFP2 mask. To assess and further discuss mask filtration efficiency for yeast and molds, we have to point out the importance of the fit (which leads to gaps) while using the face mask [15]. The effect of gaps between the face and the mask as caused by an improper fit will affect the efficiency of any face mask for any microorganism. Harmful yeast and mold spores easily spread when there is a possibility of any gap.
Figure 4.
Grown colonies of aerobic mesophilic bacteria on (a) tryptic soy agar (TSA), (b) chromogenic Agar, (c) after hemolysis on blood agar, and (d) the grown colonies of yeasts and molds on Sabouraud agar (SA) in the control group after air filtration with cloth, surgical, and FFP2 masks. Differently colored colonies represent different bacterial species.
In order to determine the ability to retain bacteria, which included the efficiency of air filtration with single-layer cloth, surgical, and FFP2 masks at different locations, PCA analysis was used. A total of 396 pooled data sets were incorporated into the analysis (11 bacterial types × 3 replications × 3 types of masks used × 4 locations). The Kasier–Gutman method and Cattell’s scree test were used to determine the number of main components (p) that remained in PCA and their contributions to the total variance. The three main components (p1, p2, and p3) were used in the analysis, and with them, it was possible to describe 91.94% of the total variance. Therefore, it can be concluded that the three main components explain the proposed model very well. Of the total cumulative variance value, the first main component (p1) explained 60.79%, the second (p2) 19.33%, and the third main component explained the remaining 11.83% (p3). Figure 5a shows the factor plane where the projections of the variable distribution (different bacteria) and cases (Figure 5b) (applied masks at different locations) are located. It can be seen that all variables (analyzed bacteria) were distributed in only two quadrants (right side of the main component p1), while the distribution of cases (applied masks in different locations) was in all four quadrants (left and right side of the main component p1). In the first quadrant of the main component p1, the following bacteria are distributed: M. luteus, A. lwoffi, S. haemolyticus, S. lentus, and S. chromogenes; meanwhile, S. aureus, S. epidermidis, Corynebacterium spp., Micrococcus spp., (Figure 5a). Bacillus spp., and yeasts and molds were distributed at the transition between the two quadrants. These facts lead to the assumption that most of the analyzed bacteria define the positive side of the p1 component.

Figure 5.
Effect of bacterial and yeast filtration with cloth, surgical, and FFP2 masks represented using principal component analysis (PCA) (n = 396 [pooled data; 11 bacterial types × 3 replication × 3 masks × 4 locations]) from locations A, B, C, and D represented by two main components (p1 and p2). Projections of (a) the variables (bacteria) and (b) cases (masks used at locations) on the factor plane.
In order to be able to confirm these results, which includes the ability to explain in more detail the effect of individual variables in the explanation of the applied model, eigenvectors and variable contribution were used. According to the data presented in Table 4, a strong positive correlation was present for the following bacterial species: A. lwoffi (0.37), Bacillus spp. (0.36), M. luteus (0.37), S. aureus (0.36), S. haemolyticus (0.33), and yeast (0.37). This indicates that they define main component p1. A negative correlation between p1 and the analyzed bacteria was not observed in any case.

Table 4.
Eigenvector spreadsheets and variable contribution based on correlations using principal component analysis (PCA) after air filtration with cloth, surgical, and filtering facepiece type 2 (FFP2) masks (n = 396 [pooled data; 11 bacterial types × 3 replication × 3 masks × 4 locations]) from locations A, B, C, and D in the three main components (p1, p2, and p3).
The remaining bacterial species were grouped around main component p2, with a positive correlation with Corynebacterium spp. (0.37), Micrococcus spp. (0.45), and S. epidermidis (0.43), whereas the correlation with S. lentus was negative (–0.46). The only bacterial type that defined main component p3 was S. chromogenes, with a strong positive correlation of 0.67. Furthermore, the individual variable contributions (Table 4) in defining the main components in PCA indicated that the variables of yeasts (0.14), A. lwoffi (0.14), and M. luteus (0.14) predominantly participated in the formation of main component p1, whereas main component p2 was most strongly influenced by the variables of S. lentus (0.21) and Micrococcus spp. (0.20). The strongest variable contribution to the formation of the main components was achieved with the variable of S. chromogenes (0.45) but only in the formation of main component p3. Analyzing the projections of the case distributions on the factor plane, it is evident that most of the observations or analyzed cases are distributed on the right side of main component p1, which leads to the assumption that surgical and FFP2 masks applied at all locations (A, B, C, and D) define the right side of component p1. The left side of principal component p1 is defined by the single-layer cloth mask at all locations.
Furthermore, the first quadrant shows the distribution of cases that have the strongest impact on the applied model, including the efficiency of air filtration, namely the application of FFP2 masks at all locations and surgical masks at locations A and C. The applied surgical mask at location B also had a significant impact on the applied model but was weaker because it is distributed in the second quadrant. The surgical mask at location D and the single-layer cloth masks applied at all locations were weak or ineffective in filtering bacteria. Meanwhile, the comparison of the variables and case distribution presented in Figure 5a,b indicate that FFP2 and surgical masks (except at location D) proved to be effective in filtering all analyzed bacteria. It should be noted that yeasts and Bacillus spp. were completely filtered by the applied FFP2 and surgical masks. Furthermore, by using FFP2 and surgical masks, good filtration of the following bacterial species was achieved: S. aureus, M. luteus, and A. lwoffi. Finally, it can also be observed that single-layer cloth masks have a very poor ability to filter the analyzed bacteria and should be replaced by either surgical or FFP2 masks. Figure 6 shows a three-dimensional (3D) surface plot showing the effectiveness of bacterial filtration (Bacillus spp., A. lwoffii, and S. aureus) with single-layer cloth, surgical, and FFP2 masks from locations A, B, C, and D obtained using PCA. The 3D surface and contour plots represent a response surface with a simple maximum. The plot shows the responses between the analyzed bacteria with different colors, from lighter to darker, together with the numerical response values (from <–460 to >100). As the color becomes darker, the response increases. It can be concluded that there was effective filtration of bacteria achieved with the FFP2 masks at locations B, C, and D and with the surgical masks at locations A, C, and D since the case data (masks used at locations) are clustered in the dark-colored area (between 40–100) and form the maximum on the 3D plot.

Figure 6.
Three-dimensional surface plot showing the effectiveness of bacterial filtration (Bacillus spp., Acinetobacter lwoffii, and Staphylococcus aureus) with cloth, surgical, and FFP2 masks from locations A, B, C, and D obtained using principal component analysis (PCA).
Some other studies performed on various methods came to similar results and observations, concluding that wearing surgical or FFP2 masks substantially reduces the number of bioaerosol particles emitted from human respiration. In contrast, the efficacy of the single-layer cloth mask is not as clear and complete for the protection and prevention that could be achieved [25,26,27].
Furthermore, it should be mentioned that the concentration of bacteria at an indoor area increases if the protective masks are not used correctly. Therefore, filtering effectiveness can depend and vary during the time spent in a given area. Some investigations mentioned that masks with lower filtration efficiency, such as single-layer cloth masks, may produce a false sense of protection [28]. Yet, the filtration efficiency of the masks depends also on the characteristics of the materials, such as chemical structure, number of layers, pore size, fibre organization, thickness, and diameter, packing density etc. [29]. Other authors point out that the quality of “fit” should be taken into account to minimize the leakage of air between the mask and the contours of the face [1]. The same conclusion conducted the researchers from an another study where the priority in product development should be given to establishing a better fit that would eliminate or minimize the face seal leakage. Also, the same investigation concluded that the future efforts in designing new respiratory protection means for different environments should be increasingly focused on the peripheral design rather than on the further improvement of the filter media [30]. This statement applies equally to the air sampler used in this study, and we should consider the possibility that this factor could also have influenced the results of the research.
4. Conclusions
In this study, the indoor air content of bacteria, yeast, and mold and the filtration efficiency of three different commonly available face masks in children’s educational institutions were studied. The bacterial contents of the genera Staphylococcus and Micrococcus were dominant in all samples, whereas bacteria of the genera Bacillus, Acinetobacter, and Corynebacterium were identified at a significantly smaller number. Bacterial filtering effectiveness increased from the single-layer cloth mask, which proved to be the least effective, to the surgical mask, to the FFP2 mask. Similar results were achieved with the filtration of yeasts and molds. Our investigation indicated that mask wearing could help mitigate droplet-associated expiratory activities, but the type of face mask protection in indoor spaces at this challenging time should be chosen wisely. In addition, the importance of the fit while using the face mask will affect the efficiency of any face mask. Therefore, it is important to further study the effectiveness of protective measures against public and occupational exposure and the transmission of infectious diseases.
Author Contributions
Conceptualization, Ž.L., D.T.L. and G.B.; methodology, N.F.; software, D.B.; validation, N.F., G.B. and S.P.Ž.; formal analysis, N.F., G.B. and G.C.; investigation, Ž.L. and L.R.; resources, D.T.L.; data curation, D.B.; writing—original draft preparation, Ž.L., D.T.L. and D.B.; writing—review and editing, D.T.L. and D.B.; visualization, L.R. and Ž.L.; supervision, D.T.L., S.P.Ž. and D.B.; project administration, G.C.; funding acquisition, Ž.L. All authors have read and approved the final draft, discussed the results, and contributed to the final manuscript. All authors have read and agreed to the published version of the manuscript.
Funding
This study was supported by a grant from the University of Rijeka, Croatia (grant no. Uniri-biomed-18-155-1304).
Institutional Review Board Statement
Not applicable.
Informed Consent Statement
Not applicable.
Data Availability Statement
Raw data were generated at the [Teaching Institute of Public Health of Primorje-Gorski Kotar County]. Derived data supporting the findings of this study are available from the corresponding author [D.B.] on request. We agree to the full transparency of the data if needed. For data related to this article, please contact D.B. (dalibor.broznic@medri.uniri.hr) and D.T.L. (dijanatl@uniri.hr).
Acknowledgments
The authors would like to thank the staff of the Teaching Institute of Public Health of Primorje-Gorski Kotar County, Croatia, for their help in sampling and analysis.
Conflicts of Interest
The authors declare no conflict of interest.
References
- Konda, A.; Prakash, A.; Moss, G.A.; Schmoldt, M.; Grant, G.D.; Guha, S. Aerosol Filtration Efficiency of Common Fabrics Used in Respiratory Cloth Masks. ACS Nano 2020, 14, 6339–6347. [Google Scholar] [CrossRef] [PubMed]
- World Health Organization. Advice on the Use of Masks in the Context of COVID-19: Interim Guidance. 6 April 2020. Available online: https://apps.who.int/iris/handle/10665/331693 (accessed on 10 May 2022).
- Allen, J.G.; Ibrahim, A.M. Indoor air changes and potential implications for SARS-CoV-2 transmission. JAMA 2021, 325, 2112–2113. [Google Scholar] [CrossRef] [PubMed]
- Persily, A. Challenges in developing ventilation and indoor air quality standards: The story of ASHRAE Standard 62. Build. Environ. 2015, 91, 61–69. [Google Scholar] [CrossRef] [PubMed]
- European Centre for Disease Control. 2019 (COVID-19) in the EU/EEA. Coronavirus Disease. Available online: https://www.cdc.gov/coronavirus/2019-ncov/prevent-getting-sick/about-face-coverings.html (accessed on 11 March 2022).
- CSN EN 14683+AC-2019; Medical Facemasks—Requirements and Test Methods. European Committee for Standardization: Brussels, Belgium. Available online: https://www.en-standard.eu/csn-en-14683-ac-medical-face-masks-requirements-and-test-methods/ (accessed on 11 March 2022).
- BS EN 149:2001+A1; 2009 Respiratory Protective Devices. Filtering Half Masks to Protect against Particles. Requirements, Testing, Marking. European Committee for Standardization: Brussels, Belgium. Available online: https://standards.iteh.ai/catalog/standards/cen/f440f60a-91c1-497b-815e-4e9d46436256/en-149-2001a1-2009 (accessed on 11 March 2022).
- Li, Y.; Leung, P.; Yao, L.; Song, Q.W.; Newton, E. Antimicrobial effect of surgical masks coated with nanoparticles. J. Hosp. Infect. 2006, 62, 58–63. [Google Scholar] [CrossRef]
- Bayersdorfer, J.; Giboney, S.; Martin, R.; Moore, A.; Bartles, R. Novel manufacturing of simple masks in response to international shortages: Bacterial and particulate filtration efficiency testing. Am. J. Infect. Control. 2020, 48, 1543–1545. [Google Scholar] [CrossRef] [PubMed]
- Tcharkhtchi, A.; Abbasnezhad, N.; Zarbini, S.M.; Zirak, N.; Farzaneh, S.; Shirinbayan, M. An overview of filtration efficiency through the masks: Mechanisms of the aerosols penetration. Bioact. Mater. 2021, 6, 106–122. [Google Scholar] [CrossRef]
- Jung, H.; Kim, J.K.; Lee, S.; Lee, J.; Kim, J.; Tsai, P.; Yoon, C. Comparison of filtration efficiency and pressure drop in anti-yellow sand masks, quarantine masks, medical masks, general masks, and handkerchiefs. Aerosol Air Qual. Res. 2014, 14, 991–1002. [Google Scholar] [CrossRef]
- Davies, A.; Thompson, K.A.; Giri, K.; Kafatos, G.; Walker, J.; Bennett, A. Testing the efficacy of homemade masks: Would. they protect in an influenza pandemic? Disaster Med. Public Health Prep. 2013, 7, 413–418. [Google Scholar] [CrossRef]
- Whiley, H.; Keerthirathne, T.P.; Nisar, M.A.; White, M.A.F.; Ross, K.E. Viral filtration efficiency of fabric masks compared with surgical and N95 masks. Pathogens 2020, 9, 762. [Google Scholar] [CrossRef]
- Eikenberry, S.E.; Mancuso, M.; Iboi, E.; Phan, T.; Eikenberry, K.; Kuang, Y.; Kostelich, E.; Gumel, A.B. To mask or not to mask: Modelling the potential for face mask use by the general public to curtail the COVID-19 pandemic. Infect. Dis. Model. 2020, 5, 293–308. [Google Scholar] [CrossRef]
- Rengasamy, S.; Eimer, B.C. Nanoparticle penetration through filter media and leakage through face seal interface of N95 filtering face piece respirators. Ann. Occup. Hyg. 2012, 56, 568–580. [Google Scholar] [CrossRef]
- Rengasamy, S.; Eimer, B.; Shaffer, R.E. Simple Respiratory Protection–Evaluation of the Filtration Performance of Cloth Masks and Common Fabric Materials Against 20–1000 nm Size Particles. Ann. Occup. Hyg. 2010, 54, 789–798. [Google Scholar] [CrossRef]
- Shakya, K.M.; Noyes, A.; Kallin, R.; Peltier, R.E. Evaluating the efficacy of cloth facemasks in reducing particulate matter exposure. J. Expo. Sci. Environ. Epidemiol. 2017, 27, 352–357. [Google Scholar] [CrossRef]
- Borges, J.T.; Nakada, L.Y.K.; Maniero, M.G.; Guimarães, J.R. SARS-CoV-2: A systematic review of indoor air sampling for virus detection. Environ. Sci. Pollut. Res. 2021, 28, 40460–40473. [Google Scholar] [CrossRef] [PubMed]
- Feller, W. TTable of Statistical Corrections According to Feller for the BioCapt® Microbial Impactor in Microbial Air Sampling. Particle Measuring Systems 2018. 1950. Available online: https://www.pmeasuring.com/blog/table-of-statistical-corrections-according-to-fell/ (accessed on 9 May 2023).
- MacIntyre, C.R.; Seale, H.; Dung, T.C.; Hien, N.T.; Nga, P.T.; Chughtai, A.A.; Rahman, B.; Dwyer, D.E.; Wang, Q.; Cluster, A. Randomised trial of cloth masks compared with medical masks in healthcare workers. Open BMJ Publ. Group 2015, 5, e006577. [Google Scholar] [CrossRef] [PubMed]
- Yang, P.; Seale, H.; MacIntyre, C.R.; Zhang, H.; Zhang, Z.; Zhang, Y.; Wang, X.; Li, X.; Pang, X.; Wang, Q. Mask-wearing and respiratory infection in healthcare workers in Beijing, China. Braz. J. Infect. Dis. 2011, 15, 102–108. [Google Scholar] [CrossRef] [PubMed]
- Khan, H.A.A.; Karuppayil, S.M. Fungal pollution of indoor environments and its management. Saudi J. Biol. Sci. 2012, 19, 405–426. [Google Scholar] [CrossRef]
- Erbasan, F. Brain abscess caused by Micrococcus luteus in a patient with systemic lupus erythematosus: Case-based review. Rheumatol. Int. 2018, 38, 2323–2328. [Google Scholar] [CrossRef]
- Whyte, H.E.; Montigaud, Y.; Audoux, E.; Verhoeven, P.; Prier, A.; Leclerc, L.; Sarry, G.; Laurent, C.; Le Coq, L.; Joubert, A.; et al. Comparison of bacterial filtration efficiency vs. particle filtration efficiency to assess the performance of non-medical face masks. Sci. Rep. 2022, 12, 1188. [Google Scholar] [CrossRef] [PubMed]
- Asadi, S.; Cappa, C.D.; Barreda, S.; Wexler, A.S.; Bouvier, N.M.; Ristenpart, W.D. Efficacy of masks and face coverings in controlling outward aerosol particle emission from expiratory activities. Sci. Rep. 2020, 10, 15665. [Google Scholar] [CrossRef] [PubMed]
- Qian, Y.; Willeke, K.; Grinshpun, S.A.; Donnelly, J.; Coffey, C.C. Performance of N95 respirators: Filtration efficiency for airborne microbial and inert particles. Am. Ind. Hyg. Assoc. J. 1998, 59, 128–132. [Google Scholar] [CrossRef] [PubMed]
- Li, Y.; Wong, T.; Chung, J.; Guo, Y.P.; Hu, J.Y.; Guan, Y.T.; Yao, L.; Song, Q.W.; Newton, E. In vivo protective performance of N95 respirator and surgical facemask. Am. J. Ind. Med. 2006, 49, 1056–1065. [Google Scholar] [CrossRef] [PubMed]
- Bowen, L.E. Does that face mask really protect you? Appl. Biosaf. 2010, 15, 67–71. [Google Scholar] [CrossRef]
- Košir, T.; Fric, K.; Filipić, A.; Kogovšek, P. Bacterial Filtration Efficiency of Different Masks. Stroj. Vestn. J. Mech. E 2022, 68, 225–232. [Google Scholar] [CrossRef]
- Grinshpun, S.A.; Haruta, H.; Eninger, R.M.; Reponen, T.; McKay, R.T.; Lee, S.A. Performance of an N95 Filtering Facepiece Particulate Respirator and a Surgical Mask During Human Breathing: Two Pathways for Particle Penetration. J. Occup. Environ. Hyg. 2010, 6, 593–603. [Google Scholar] [CrossRef]
Disclaimer/Publisher’s Note: The statements, opinions and data contained in all publications are solely those of the individual author(s) and contributor(s) and not of MDPI and/or the editor(s). MDPI and/or the editor(s) disclaim responsibility for any injury to people or property resulting from any ideas, methods, instructions or products referred to in the content. |
© 2023 by the authors. Licensee MDPI, Basel, Switzerland. This article is an open access article distributed under the terms and conditions of the Creative Commons Attribution (CC BY) license (https://creativecommons.org/licenses/by/4.0/).